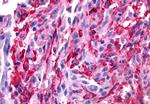

Search
Invitrogen
GALR2 Polyclonal Antibody
{{$productOrderCtrl.translations['antibody.pdp.commerceCard.promotion.promotions']}}
{{$productOrderCtrl.translations['antibody.pdp.commerceCard.promotion.viewpromo']}}
{{$productOrderCtrl.translations['antibody.pdp.commerceCard.promotion.promocode']}}: {{promo.promoCode}} {{promo.promoTitle}} {{promo.promoDescription}}. {{$productOrderCtrl.translations['antibody.pdp.commerceCard.promotion.learnmore']}}
产品信息
PA5-33575
种属反应
宿主/亚型
分类
类型
抗原
偶联物
形式
浓度
规格
纯化类型
保存液
内含物
保存条件
运输条件
RRID
产品详细信息
Percent identity with other species by BLAST analysis: Human (100%) Gorilla, Gibbon, Monkey, Marmoset, Mouse, Rat, Hamster, Bovine, Horse (94%) Panda, Dog, Bat (89%).
靶标信息
GalR2 expression has been documented widely in the brain and in peripheral tissues including small intestine, heart, kidney, and liver. Localization data from rat CNS indicate high levels of expression in dorsal root ganglia, amygdala, and Purkinje neurons. G-protein Coupled Receptors (GPCRs) comprise one of the largest families of signaling molecules with more than a thousand members currently predicted to exist. All GPCRs share a structural motif consisting of seven membrane-spanning helices, and exist in both active and inactive forms. An array of activating ligands participate in the conformation of GPCRs which leads to signaling via G-proteins and downstream effectors. Ongoing studies have also shown the vast series of reactions which participate in the negative regulation of GPCRs. This "turn-off" activity has tremendous implications for the physiological action of the cell, and continues to drive pharmacological research for new drug candidates. Two blockbuster drugs which have been developed as GPCR-targeted pharmaceuticals are Zyprexa (Eli Lilly) and Claritin (Schering-Plough) which have multi-billion dollar shares of the mental health and allergy markets, respectively.
仅用于科研。不用于诊断过程。未经明确授权不得转售。
篇参考文献 (0)
生物信息学
蛋白别名: G protein-coupled receptor; Gal receptor 2; Gal-2 receptor; Gal-r2; GAL2-R; Galanin r2 receptor; Galanin receptor type 2; Galanin-2 receptor; GALR2; MGC125983; MGC125984
基因别名: GAL2-R; GALNR2; GALR-2; GALR2
UniProt ID: (Human) O43603
Entrez Gene ID: (Human) 8811